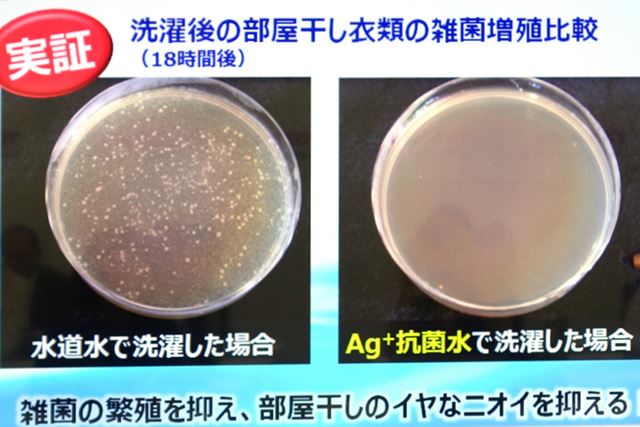

今度の「マジックドラム」は“11kg洗えて幅60cm!”のスリム&おしゃれボディが特徴
東芝ライフスタイルは、同社の人気ドラム式洗濯乾燥機「マジックドラム」の新モデル「Big マジックドラム TW-117X3」(TW117シリーズの最上位モデル)を発表した。新モデルの進化ポイントは、業界トップクラスの「大容量」化と「洗浄力の強化」、そして家事の“時短”に大きく貢献する「乾燥性能の強化」の3つ。発表会場では、新機能の説明のほかさまざまなデモンストレーションが行われたので、そのようすをレポートしよう。

新モデル「Big マジックドラム TW-117X3」。左から「グランホワイト」と「グレインブラウン」。そして、住環境などから増加する“洗濯物を見せたくない人”向けに、ドアが不透明の「インテリアホワイト」の3つのカラーを用意
ドラムは大きくなったが本体幅は1cmコンパクトに!
2012年より実施する同社の調査によると「次に欲しい洗濯機の容量」は、この3年間で「10kg以上」と答える割合が約2倍に増えているという。これは、共働き世帯のまとめ洗いの需要や、毛布やカーテンなどの大型ファブリックを自宅で洗濯する家庭が増えているためだと思われる。

同社による定期アンケートの調査結果。2012年には17%だった「10kg以上の大容量洗濯機需要」が、2015年には2倍の34%まで増えている
そこで、今回のモデルチェンジでは、洗濯物を入れるドラムサイズを大型化。ドラム径を従来より2cm大きくすることで、従来は9kgだった洗濯容量を11kgまで拡充(家庭用ドラム型洗濯乾燥機の洗濯容量として最大クラス)。さらに、洗濯機は設置スペースが限られていることをふまえ、大容量化を実現しつつも、本体サイズは幅を1cm縮小するというコンパクト化も実現している。


右が従来機「Z96X2M」、左が新モデル「TW-117X3」。本体幅は1cmコンパクトになったにも関わらず、ドラム径は約2cm拡大。ドラムの深さも深くなり、洗濯容量は従来より2kgも増えている


一度に洗濯できる量=11kgのイメージ(標準的な脱衣かご3個分に相当するという)。ドラム径が大きくなったことで、衣類の投入口もサイズアップ。毛布のような大きな洗濯物の出し入れもスムーズに行える
抗菌水と酵素の力で洗浄力パワーがアップ
ドラム径が大きくなったことで、洗浄力もアップした。ドラム式洗濯機は、洗濯物を遠心力で持ち上げて、下方向に落とすという「たたき洗い」が特徴の1つ。TW-117X3は、ドラム径が大きくなったことで「たたき落す」ための高低落差が大きくなり、より強い力で汚れを落とせるようになった。また、放出される水をの流量は、従来機よりも約40%アップ。ドラムの前後から高圧のシャワーで洗剤液を衣類に浸透させるため、洗浄力はさらにアップしたという。

ドラムが大きくなったことで、約54cmの高低差から衣類を「たたきつけて」洗浄。さらに、ドラム前後から高圧で洗剤液を吹き付けることで、効率よく衣類に洗剤液を浸透させることができるようになった
以下の動画は、約40%流量がアップしたTW-117X3と、従来機Z96X2Mのシャワーのようすを比較したもの。TW-117X3のほうが明らかに水の勢いが強いのがおわかりいただけるだろう。さらに、水道水を「Ag+抗菌水ユニット」に通過させることで、洗濯やすすぎには銀イオンが溶け出した「Ag+抗菌水」を使用できる。このAg+抗菌水を使用することで、衣類の雑菌の繁殖が抑えられるのも特徴だ。このため、ただ衣類の汚れを落とすだけではなく、部屋干しをした際のイヤなニオイまでも抑えられるという。
水道水で洗濯した衣類と、Ag+抗菌水で洗濯した衣類の菌を18時間培養した実験結果。Ag+抗菌水側は、菌の繁殖がほとんどみられなかった
頑固な皮脂汚れには、約40℃に温めた洗剤液に衣類をつけおき洗浄もできる。皮脂は約37℃以上の温度帯から溶ける上、40℃前後の温水は、洗剤の酵素を活性化させて洗浄力を強化できるという。このため、従来の洗濯機では落ちにくいとされていた、皮脂による「黄ばみ汚れ」がスッキリと落とせるという。
また、TW-117X3はこの40℃のつけおき洗浄のほか、染みついた汚れも落とす60℃の高温洗浄、さらに、汚れが落ちにくくなる冬場に重宝する15℃洗浄の、3種類の温度帯による温水洗浄が可能だ。

本体内部には、温水洗浄のためだけに利用される専用ヒーターを搭載。乾燥時のヒーターと併用しないことで安定した湯温を保てるという

40℃のつけおき洗浄をしたシャツの洗浄前と洗浄後を比較。「黄ばみ汚れ」がきれいに落ちているのがわかる
風の力で衣類を広げ、シワを防いでフンワリ仕上げ
ドラムの大型化により、乾燥時に衣類がドラムのなかで広がりやすくなったのも特徴のひとつ。さらに、従来はドラム中央に向けて吹き付けていた温風を、ドラム上方に向けてあてるようになった。一般的に、乾燥中の衣類はドラム上部に広がりながら舞い上がる。この「衣類が一番広がった状態」のときに強い風をあてることで、衣類のシワを伸ばす効果があるという。

従来はドラム中央に向けられていた温風を、TW-117X3はドラム上部に向けて吹き付ける。衣類が一番広がっているタイミングで強い風をあてることでシワを伸ばす効果がある

会場には、TW-117X3で乾燥させた綿素材のYシャツとパンツも展示されていた。左から1kg、3kg、7kgの衣類と同時に乾燥したもの


風を送るためのファンも大型化し、約30%ほど風量がアップ。写真上がTW-117X3、下が従来機のファン。TW-117X3の羽根は、大型化した分だけホイールから飛び出ている
また、乾燥には低温でも素早く乾燥が可能な「新・ヒートポンプユニット」を採用。ヒートポンプ式とは、湿気を含んだ空気を、熱交換器を通して除湿する、エアコンなどにも利用されるシステム。熱で衣類を乾燥させる一般的な「ヒーター式」と比較すると、ヒートポンプ式は低温で効率よく除湿ができるほか、節電、節水効果も高い。低温の風で繊維をふっくらと仕上げるほか、熱による生地のダメージが少ないのも特徴だ。
さらに、TW-117X3は従来機よりも熱交換器の表面積を約2割広げており、除湿効率もアップ。ファンの大型化により風量も大きくなったため、従来機と比較して乾燥時間も短縮可能。「お急ぎモード」ならば約95分という短時間で乾燥が終了する。

TW-117X3は従来機よりも熱交換器の表面積を約2割広げており、除湿効率もアップ

衣類をふっくら乾燥させる「ふんわリッチ」乾燥により、タオルなどは天日干しをするよりも柔らかくふっくらと仕上がるという
少ない衣類の“脱水時の失敗”も解決
ドラム式洗濯機で少量の衣類を脱水すると、高速回転時に衣類がドラム内で片寄りやすい。衣類が片寄ったままドラムが高速回転すると、洗濯機本体が大きく振動して危険だ。このため、従来までの洗濯機は振動が大きくなると脱水を一度中断し「水を追加して衣類をドラム内で広げる」「再脱水」という手順を踏んでいた。しかし、TW-117X3は「新振動吸収クッション」の採用で、少量の洗濯物の脱水でも、振動を抑えることに成功。脱水の中断による、水や時間のムダを抑えられる。また、振動吸収クッションで洗濯乾燥機本体の振動を抑えることで、静音性も高くなっている。

衣類がドラム内で片寄ることで、水や時間の無駄になることも。また、何度やり直しても衣類が片寄る場合は、脱水できずにエラーで洗濯を続行できないこともある

「新 振動吸収クッション」。振動を受け止めて、横揺れを抑える「高減衰ゴム」と、電流のON/OFFで固さが変わる「MR流体」によって構成されている
会場内では、通常のゴムと高減衰ゴムの揺れの違いを体験できるキットが用意されていた。以下の動画で、高減衰ゴムは瞬時に横揺れが止まるが、通常のゴムは長く揺れ続けているのがおわかりいただけるだろう。
忙しい人の味方になる「使いやすさ」を追求した機能とデザイン
機能たけでなく、デザイン性の高さも特徴の1つ。本体にはガラス素材が使用されており、高級感があるほか汚れが落としやすい。また、洗濯機のトップには「入」「切」の2つのボタンのみを配置。電源を入れると、必要なメニューだけが光って表示される「スマートタッチパネル」を採用している。

本体上部には、「入」「切」の物理ボタンを配置。電源が入ると、必要なメニューだけが光る

槽内が視認できる透明ドアモデルのほか、中に入っている洗濯物が見えないように配慮された不透明ドアを採用する「インテリアホワイト」モデルも用意
面白いのが槽内にLEDを配置している点。ドアを開けるとLEDが点灯するため、洗濯槽の奥までよく見え、衣類の取り忘れを防げる(インテリアホワイトモデルのみ、運転中の槽内LED点灯はありません)。

ドアを開けると槽内LEDが点灯。洗濯物の取り忘れを防止してくれる。なお、洗濯中に槽内を観察できる「照明」メニューもある
また、製品の名前にもなっている「マジックドラム」にも対応。これは、特殊コーティングにより、洗剤カスなどの汚れが水で簡単に流れる機能。黒カビや雑菌の原因となる汚れがつかないため、いつでも槽内を清潔に保つことができる。会場内では、マジックドラムと同じ素材のパネルと一般的な洗濯槽素材のパネルにマジックで落書きをし水をかけて、その性能をアピールするデモンストレーションが行われていた。
>> 今度の「マジックドラム」は“11kg洗えて幅60cm!”のスリム&おしゃれボディが特徴 の元記事はこちら
